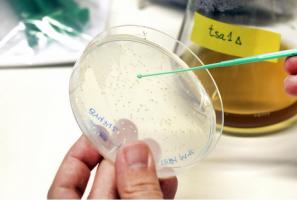
La levure constitue un bon système modèle pour étudier le vieillissement cellulaire (Visuel Martina Butorac/Chalmers University of Technology)

RESVÉRATROL et autres ANTIOXYDANTS : Pourquoi le raisin est un superaliment
Cette nouvelle étude, soutenue par la California Table Grape Commission, nous explique à nouveau pourquoi le raisin frais est un superaliment. Plus largement, l’article, publié dans le Journal of Agricultural and Food Chemistry, explore ce concept de « superaliment ».
Pour continuer à lire cette actualité, vous devez être membre Premium.
Je souhaite devenir membre PREMIUM
Accèdez sans limite aux 15 000 actualités du site et recevez gratuitement chaque semaine, la Newsletter Santé log avec les actus Santé à ne pas manquer !
Je suis déjà
membre PREMIUM
Devenez membre PREMIUM
Accèdez sans limite aux 15 000 actualités du site
et recevez gratuitement chaque semaine,
la Newsletter Santé log avec les actus Santé à ne pas manquer !

Je suis déjà membre PREMIUM
Autres actualités sur le même thème
ANTI-VIEILLISSEMENT : Un peu d'oxydants mais pas trop
Actualité publiée il y a 5 années 4 moisCHOLESTÉROL : Quelques repas de fêtes suffisent
Actualité publiée il y a 7 années 3 moisNUTRITION : Pourquoi il faut veiller aux grains
Actualité publiée il y a 5 mois 2 semainesGRAISSES SATURÉES: Un peu, pas trop, elles peuvent être bonnes pour la santé
Actualité publiée il y a 9 années 4 mois
ABONNEMENT PREMIUM
Accédez sans limite à plus de 15 000 actualités